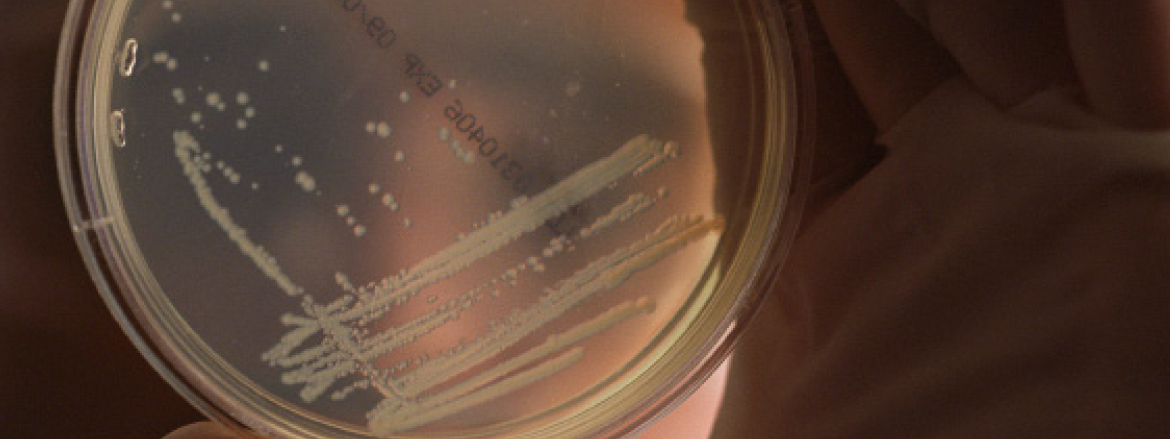
Konuya ait resim

Şiir

Gül Kırmızı ve Aşk Sızı
Sen gittin, hazan düştü bahçemizeSen gittin, tarumar oldu her şeySen gittin, geriye doyumsuz bir aşk bıraktın bize. Sevgili!önce kum deryalarına düştük sonra serâbabugüne kadar umutlardı bizi ayakta tutansevdandı kimsesiz çöllerde yürekleri bir tutan,yalnızlığa açılır bütün
[Devamını Oku]

Yalnız Kur'ân konuşsun!
Susun, susun ey insanlar, dinleyin bir ses var Kâinat mescidinde hak söz Kur'ân okunur Her şey sussun o konuşsun, nefis sussun akıl sussun Kelâm-ı ezelîyle yalnız Rabbim konuşsun Âlemlerin Rabbi sıfatıyla konuşan ey Rabbimiz Her
[Devamını Oku]

Çanakkale'nin İsmâillerine
Gidin ve görün...Toprağı hâlâ kırmızıdır Çanakkale'nin. 'Tüfek îcâd oldu, mertlik bozuldu'demişti şâirŞâirim! Peki gördün mü Çanakkale'yiÖlüme ölümsüzlük nâmını verenleriAsrın İsmâillerini gördün mü şâirim Savaşın efendisi bir milletin sînesindeSır perdesi ardında bitimsiz îmânTufandı, kıyâmetti martın on
[Devamını Oku]

Korkunç Cehâlet Vardır
Kardeş, zikrin efdali "Lâ ilâhe illallah!Muhammedün Resulullah" diyene cennet vardır!Muhammedsiz gönüller asla bulmadı felah,Onu tasdîk edene ebedî felah vardır! Allah, Ehad, Samed'dir, elçisi Muhammed'dir!Tevrat, Kur'ân'da mezkur, İncilde de Ahmed'dir. Enbiyâ sonuncusu, makamca serâmeddir!Resulsüz çorak kalpte
[Devamını Oku]

Bir şehid ailesinin hikâyesi: Zalimler için yaşasın cehennem!
Ebu Hureyre (ra)'dan rivâyetle Resulullah (asm) buyurdu ki: Şehidin duyduğu ölüm acısı herhangi birinizin duyduğu çimdik acısı kadardır. (Tirmizî, 1326) Hani bir de Nemrut, İbrahim (as)'ı da ateşe atmıştı da, ateş de onun hakkında gül
[Devamını Oku]

El amân Yâ Resulallah!
Rabbimizin emriyle Sur'a üfürülünce,Mavi gökler dürülüp dağlar yürütülünce,Altta Gayya kor alev, üstte Sırat zor ince,O dehşet an çatınca elimden tutar mısın? Beşer Haşr-i Ekber'e bölük bölük akarken,Ana kızdan, babalar oğullardan kaçarken,Kimisi sürünürken kimileri uçarken,Mübarek kanadını
[Devamını Oku]

Nur Muhammed (asm)
Âmine ve Abdullah ne bahtiyâr idi ki:En güzel hediyeyi, Allah onlara verdi.Kim mi? Merak ettin mi? Söyleyeyim mi?Nur Muhammed Mustafa'yı, Emin'i Nur, beş yüz yetmiş birde, Mekke'de doğdu.Nur, Kadir Gecesi'nde peygamber oldu.Dün, bugün ve de
[Devamını Oku]

Ve Geldin
VE GELDİN EY NEBÎGeldin de âleme verdin teselli.Zira âlem-i bekasız nasıl teskin olunur ki,Saplanırken kalb-i hazinimize fena hançeri;Her dem çekerken elvedasız gidişlerin firak elemini. Geldin de:Kainatın dizginlerini aldın emin ellerine,Bahr-ı zamandaki seyahat-i meçhule-i beşeriyyeVe inkıraza
[Devamını Oku]

Vahye etmek istinad!
Ey zerrât, seyyarâtın yegâne müdebbiri! En cesim varlıkların sana mutî her biri. Kâinatta her şeyin elindedir tedbiri, Nasıl kavrasın akıl, o Hallâk-ı Kebîri? Kalpler tatmin mi olur, almayınca tekbîri?! Akıl, fikir de mahluk, çünkü edilmiş
[Devamını Oku]

Münâcât
gündüzü geceye cevâb eylediner-sultan demeden türâb eyledinbin yıllık Firavunu harâb eyledinbizleri ‘biz'likten ayırma yâ Râb! mal ve mülk senin, ben fakîr kulunumharamlarla hemhâl hakir kulunumaffeyle, isyanda mâhir kulunumyine de duâdan ayırma yâ Râb! ister bir
[Devamını Oku]

Solmayan Aşk!
Gönül kulağınıza gelen bir musikî mi var alemden?İşte; zerresinden güneşlerine ‘Aşk' diyor bu alem.Aşkın bestesini yapıyor, güftesini okuyorVe adeta kainat gergefinde ‘Aşk' dokunuyor..Kalb-i insan da bu ahenge dahil olmuş,Ve ‘Aşk.. aşk' diyerek, aşka müptela olmuş.Aşkla
[Devamını Oku]

Hacc İle Yeniden Doğuş
Cennet ucuz değildir. Cefasız sefa olmamaktadır. Sabırla aşılmalıdır her engel. Bunlar başarıldığı takdirde ise işte yüce Nebi'nin müjdeli haberi: Makbul bir hacc, dünya ve dünyadaki her şeyden daha iyidir. Ona cennetten başka karşılık verilmez. (Buhari,
[Devamını Oku]

Davetine İcâbet Edenlerden Kıl Bizi
Şimşekten hızlı geçer sayılı günlerimiz, Davetine icâbet edenlerden kıl bizi! Sanki matem kesildi şenlik, düğünlerimiz Davetine icâbet edenlerden kıl bizi Çağımız ayırt etmez oldu helal, haramı, Sofilerin birçoğu hatırlatır bel'amı, Unutturuldu şu genç kuşağa Rabbin
[Devamını Oku]

Gazze'de yaşamak
Ağzı varsa sözü yok ki küçük dilinde Ahuzarı yas bürünmüş inler kalbinde Zulme rıza gösteren de zulmün içinde Gök yarılsın perde kalksın azap yerinde Zir-ü zeber etsin Allah, en yakın günde  Bir sabidir gördüğüm…
[Devamını Oku]

Acılar Bitsin Artık!
Çağdaşlık budur deyip arz döndü kan gölüne, Hak-hukuk kilitlendi atomun kapsülüne! Medeni denen dünya döndü vahşet çölüne, Şeytan, her askeriyle yeni role soyundu! Bize vaat ettikleri, bütünüyle oyundu! Ateşe verdiler büsbütün dağı, ovayı, Hatta yaşanmaz
[Devamını Oku]

Rahmet Gemisi
Anne bak! Ufukta görünen gemi,Limana yanaştı. Bak geminin ismi ne güzel. Rahmet gemisi. Kaptan, Rahmân-ı Hannân. Tayfalar, Gökyüzündeki yıldızlar. Hadi anne bizde binelim. Korkma! Bu kaptan ile alabora olmaz, Rahmet gemisi. Hem bu kaptan görmüş,
[Devamını Oku]

Aşure
KUR'ÂN HÂMİLİ Abdullah b.Mesud (ra) der ki: Kur'ân hâmili, İnsanlar uykudayken, gecelerini değerlendirmesiyle, İnsanlar iftar ederken, (oruç tutarak) gündüzünü değerlendirmesiyle, İnsanlar her şeye atılırken, verâsı ile, İnsanlar kurnazlık yaparken, tevazusu ile İnsanlar sevinçli iken hüznü
[Devamını Oku]

Çekilip nur-ı hidâyet…
Çekilip nur-ı hidâyet, yine zindan olacak Yine firkat, yine hasret, yine hüsran olacak, Yine sen, yaş yerine kan akıtıp ağla gözüm, Çünki hicran dolu kalbim, yine hicran olacak. Yine göç var diye, mecnuna haber verme
[Devamını Oku]

Birliğinin ışığında erit beni!
Ateşi bilmenin bedeli nedir? diye sorduklarında Alevinde bir kez olsun yanmaktır. demişlerdi. Bir'i bilmenin bedeli ben her ne ise razıyım. Bütün Hayır!larımı yok eden bir ateşte yak beni! Ey Bir! Sadece bir tek Hayır!ı alma
[Devamını Oku]

Üç Çınarın Hikayesi
Ah! Serin toprağa düşen çınarlar...Bu dağlar sizi rahmetle anarlar,Ses versinler Sav'dan akan pınarlar. Elveda dediler, Hakk'ın erleri;Bir Cuma sabahı aldık haberi. Günleri, asırlık zaman olanlar,Nur yoluna nurlu kervan olanlar,Ey karanlık geceye tan olanlar! Sema deryasının
[Devamını Oku]

Ya Müheymin!
Nihayet kendime geldim de… Sana geldim. Huzurundayım. Yoğun korkularımla, Derin sevgilerimle, Cayır cayır yanan yüreciğimle sana geldim. Kollarını açmış beni mi beklersin? Ne kadar da yücesin! Oysaki pis kokular saçanHatalarımla,Kusurlarımla,Fiillerimle,İhtiyarımla,Ateşe layık nefsimle,Ruhumla,Cesedimle sana geldim. Ben
[Devamını Oku]

Kalemle hasbihalve kaleme arzuhal
Dertten anlar kaleme dertlerimi dinlettimBir ağaç parçasıyken derdim ile inlettimEy beyaz sahifeler, yazdım kara yazımıBu kara bahtın kara yazısıyla kirlettim Kimseler bilmez iken kalbime girip bildinHer ne söylersem sana anlatmaya kâbildinEy derdimin ortağı ey gönlümün
[Devamını Oku]

İki Deniz
Filistin’de iki deniz varmış. Bu denizlerden birinde balıklar yaşarmış. Bu denizin suları masmavi ve tertemizmiş. Bu denizin hemen yanı başında olan diğer denizin suyu mavi değil, kirli renkliymiş. O denizin içinde balıklar yokmuş. Kıyılarında insanlar
[Devamını Oku]
Hücrelerimiz
Vücûdumuzdaki yaklaşık 200 çeşitli tipteki hücrenin aralarındaki en önemli farklılık şekilleridir. Bunların hepsi temelde aynı mekanizmalara sâhib olmalarına rağmen, mükemmel şekilleri ile görev yaptıkları bölgede en yüksek verimi alacak şekilde yaratılmışlardır. Farklı şekillere sâhib hücrelere
[Devamını Oku]

İnşirah Sancısı
Sussam dudaklarım kanar… Yorgun kelimelerin ardında saklıydı düşlerimGök yarılacak ve şerha şerha -Rahmet avuçlayacaktı gözbebeklerimOysa ne çok üşümüştü tarih ve zamanAnlamadan anlaşılmak mümkün değildiBiliyordum Sağır yürekli yaftalarla dolu renkli bezirgânlarAslından etti aslımızıNice inşikaklar uğradıNice depremler
[Devamını Oku]

Ey Masum Ve Güzel Evladım
Ey ma‘sûm ve güzel evlâdım!Ey temizlerden de tertemizgünahsız çocuğum.Seni Allah’ın rahmetineemânet ediyorum,Ve öyle de bırakıp gidiyorum,Rabbim, seni ve hayatınımes‘ud ve bereketli kılsın.Anneciğinin yokluğundanhiç üzüntü duyma.Sen Allah’a emânetsin. Ey bir rüyanın kurbanı olacakken,Allah’ın lütfu ve ikrâmı
[Devamını Oku]

İnşirah
Dokunsam çoğalır sızılarımEllerim kan revanVe bir deprem öncesi telaş içindeyimSusmak istemiyorumViran olmuş zamanların sevdasıyla Haramiler uğradı bu şehreTadılmadık zulüm bırakılmadıVe yaşanmamış cehennemNeredeydiniz siz efendiler Sussam bir daha açılmaz dilimŞair; ‘sussam dudaklarım kanar’ demişti Benden size,
[Devamını Oku]

"Öldürdüklerini Dirilteceğin Güne Kadar..."
Yâ İlâhenâ! Aslın nûrânî ağacı, Rahmânî kudretin, mülk ve tasarrufâtın parıltısı, İnsan olarak yaratılanların en fazîletlisi, Cismânî sûretlerin en şereflisi, Rabbânî sırların menbâı, en seçkin ilimlerin hazinesi, Asıl mülk ve tasarrufun, göz kamaştıran parlak güzelliğin
[Devamını Oku]

Yine Gördüm Sizi
Yine gördüm sizi bir dâr-ı naîm kasrındaBa’del üstâd sen idin ferd-i ferîd, asrında Seni en fazla sitâyiş ediyor ÜstâdınGeçiyor Türke halâskâr diye Nûrlarda adın Zâtın olmuş Bedi’üddeverânın halefiSa’y ve azminle, cihâdınla şaşırttın selefi Ve bu
[Devamını Oku]

Mukaddime
Bir zamanlar fânilerden usandım Def-i gam kaydıyla çok şeyler yazdım Ruhumdaki boşluk dolacak sandım Şiir tarlasını kazdıkça kazdım Hassan bin Sâbit’le Kaab bin Züheyr’i Rabbim kıldı nurlu şiirin rehberi Busîrî, Ferazdak gibi erleri Düşündükçe sanki
[Devamını Oku]

İrsâl-İ Rusül Gerçeği
ارسال رسل كرچگي لطفڭله دوزلت نفسمي، روحم نَفَس آلسين لاهوت ايلنڭ نور طولی اقليمنه دالسين ديدارينى عرض أيله كه حيران باقا قالسين اڭ سوگيلينڭ حرمتنه حكمڭه رام ايت خوشلانمدیغڭ هر نه كه وار، قلبه حرام
[Devamını Oku]

Apayrı Lütuf
Şu alıp verdiğimiz her nefes apayrı lütuf Bunca ni’metleri bahşetmiş olan Rabb-i Atûf Bekliyor bizden evet, hamd ü senâ, istihsân Ne büyük ârdır, eğer bulmasa ma’kes ihsân Kulluğun gayesidir zikr ve fikr, şükr ve dua
[Devamını Oku]

Bilmemek Cehaletmiş
Birkaç günlük fânîyi, mülk-i bâkî sanmıştım Bilhassa genç yaşlarda sâfdilâne kanmıştım Azıcık yaşlanınca hayâttan usanmıştım Zîrâ haddinden fazla yaktı firâk elemi Bulamamıştım kalbe aradığım merhemi Kendimle birlikte her nesne kalsın berhayât Yanaşmasın kat’iyyen bize ecel
[Devamını Oku]

SÜLEYMANİYE

Mekteb-i İrfâna İlerle

Bilmemek Cehâletmiş
Birkaç günlük fâniyi, mülk-i bâkî sanmıştımBilhassa genç yaşlarda safdilâne kanmıştımAzıcık yaşlanınca hayattan usanmıştım Zira haddinden fazla yaktı firak elemiBulamamıştım kalbe aradığım merhemi Kendimle birlikte her nesne kalsın berhayatYanaşmasın kat'iyyen bize ecel ve mematFakat öyle değilmiş
[Devamını Oku]

Üstad Bedîüzzaman
Suçu neydi ki O'nu şehir şehir dolaştırdılarHapse atmak için inceden inceye araştırdılarYemeğine zehir katıp öldürmeyi kararlaştırdılarHayatı zindanlarda geçen Üstad Bedîüzzaman. Minnet altında kalmamak için hediye kabul etmediDünyayı elinin tersiyle itti, Karunların yolundan gitmediVarlık peşine düşüp
[Devamını Oku]

Hayal Ülkesinden Bir Değer: Şiir Gözlüğüyle Hayat ve Kâinat Kitabını Okumak
İne gönül, kalka gönülHep doğruya baka gönülHak vergisi… Hakk’a gönülVermeyene anlatılmaz. İlk ne zaman bir şiir mısrasıyla karşılaştık? Şairin hayal dünyasının sınırları ve sırları ne vakit açıldı gönül dünyamıza? İlk şiirimiz hangisi? İlk fark ettiğimiz
[Devamını Oku]

Şiir Onu Arar
Meşhur bir vecize vardır: “Arayanlar bulamaz; bulanlar arayanlardır.” İnsanoğlu her daim bir arayış içine girmiştir. Bazen varlığını bazen de var olmak üzerinden var etmenin arkasındaki sırrı sorgulamıştır. Bazıları bu arayışta kaybolmuş, bazıları insan-ı kâmil mertebesine
[Devamını Oku]

Berceste (2)
Cemal-i hüsnünle mağrur olursunKemal-i hüsnünün noksanı yok mu? Hoca Dehhani Tevazu sahibi olmak Şair bir tecahül-i arif yapar sezdirmeden. Bildiği halde bilmezlikten gelir. Cemal-i hüsnünle mağrur olursun derken aslında “Mağrur olma!” der, bizlere. Yine kemal-i
[Devamını Oku]

Değerleri Şiirleştiren Şair
Vefatının sene-i devriyesi münasebetiyle... Hayır, hayal ile yoktur benim alışverişimİnan ki, her ne demişsem görüp de söylemişim “Eşek ölür kalır semeri, insan ölür kalır eseri” demiş ecdad. Bize yadigârı olan bu kısacık sözde, aslında kişinin
[Devamını Oku]

Buyruğuna Râm Ettir
Nefsimin serkeşliği artık canıma yetti Ya Rab, şu mahlûkunu buyruğuna râm ettir Ona zehirli şarâb bir zamanlar şerbetti Senden ayıran zevki gönlüme haram ettir Senin rızân dışında kimi neyi sevmişsek Ebede giden yolda oldu ayağa
[Devamını Oku]

Durmayalım*
*Mehmet Akif ERSOY
[Devamını Oku]

Hakkın Sesleri*
*Mehmet Akif ERSOY
[Devamını Oku]

A Nefsim

Gâye-i Hayâl

Apayrı Lütuf

Utansın*
*Necip Fazıl KISAKÜREK
[Devamını Oku]

Senin İçin Yaşat, Öldür

Sakarya Türküsü*
İnsan bu, su misali, kıvrım kıvrım akar ya; Bir yanda akan benim, öbür yanda Sakarya.Su iner yokuşlardan, hep basamak basamak; Benimse alın yazım, yokuşlarda susamak.Her şey akar, su, tarih, yıldız, insan ve fikir; Oluklar çift;
[Devamını Oku]

Yakarış

Kelam-ı Ekber

Rabbenâ Ya Rabbenâ!
Rabbenâ yâ Rabbenâ çok lûtfettin insana!Hem gizli, hem açıktan boğdun bizi ihsâna!Birçoğumuz düşünmez, dalar türlü isyana!Bilmez ki; her nankörü kapatırlar zindana! Tevhidsiz felsefeci, bırakırmış zulmette,Bundan hüküm sürmekte harp, kargaşa ümmetteYalnız şakî müstesna, zerre-kürre hizmetteKalpler, vicdanlar
[Devamını Oku]

Daimi Zikrullahla Memurdum
Kötü hal ve ef’alim düşürdü şu hallere Deli gibi şenlendik dalınca veballere! Hâdî ism-i şerifin tecelli etsin artık! Yıllarca me’yus baktık ufka, istikballere Nefsimdeki hatalar kuşattı her yanımı, İnsi, cinni şeytanlar sulattı izanımı, Yanlış düşüncelere,
[Devamını Oku]

Kalplerin Şirâzesi
Bir pazartesi geldi bize en kutlu haber Kalemim ki secdede yüreğimle beraber. Sen geldin de Şirâze’m, kâinata can geldi Rahmet dudaklarından ölümsüz derman geldi Baba eliyle bir kız atılırken çukura Yıllardır beklenilen lâhutî ferman geldi.
[Devamını Oku]

Hizmetkar
Parçalandı insanlık; dağıldı evim, yurdum,Zulmet serpildi yere, seni arayıp durdum. Dünyalık derdin yoktu, gâyen îmânlı nesil,Cihanı aydınlatan Kitab’tır sana kefil. Yayıldı ilk beşâret Nurs’tan, Bitlis’ten, Van’danÖlüm gelse de seni vazgeçirmez davandan Atıldın zindan zindan, sürgün
[Devamını Oku]

Üstad
ÜSTÂD Cavid Saraçoğlu Nûr ordusunun sürûr-ı zî-şânıdır Üstâd Can mülkünün en sevgili cânânıdır Üstâd Yakûb dilinin Yûsuf-ı Kenân’ıdır Üstâd Şefkat bağının bülbül-i nâlânıdır Üstâd Hak yol budur, isyâncı ve gümrâha yanaşma Nûr mesleği havuzundan ebed
[Devamını Oku]

Ravza-i Mutahhara’da Bekleyen Ruhlar
(Edebi terk etmekten sakın! Zira burası Allah’ın habibinin beldesidir. Burası, Hak Teala’nın devamlı nazar kıldığı bir yerdir; Muhammed Mustafa’nın (sav) makamıdır. Ey Nâbî, bu dergâha edebin şartlarına dikkat ederek gir! Sakın edebi basite alma! Burası
[Devamını Oku]

Nurun Yılmaz Hizmet Erleri!
Ey, Nur’un yılmaz hizmet erleri!Hep mâni olmak ister, size birileri;Sebat edip, gitmediniz hiç geri;Hiç kurumadı alnınızın teri. Evde hizmet; yolda hizmet; işte hizmet;Hakiki, riyasız, halis; budur işte hizmet! Ne bir beklenti ne bir menfaati var;Vefakâr,
[Devamını Oku]

Berceste (3)
Cihân ârâ cihân içredir ârâyı bilmezler O mâhiler ki deryâ içredir deryâyı bilmezler. Hayâli Kıymet bilmeyişimiz, kıymetli oluşumuzu anlamayışımız yeni değil. Mezarlıklar “eyvahlarla, keşkelerle” dolup taşar. İnsan soyu elde edemediklerine yanar durur da elde ettiklerinin
[Devamını Oku]

Kadim Bir Şiir: İstanbul
İstanbul kadim bir şehirdir, İstanbul şiir gibi bir şehirdir ve İstanbul kadim bir şiirdir.Mekke, Medine, Kudüs, Semerkand, Buhara, Yesi, Kerkük, Şam-ı Şerif, Tebriz, Isfahan, Bursa, Konya… Ve İstanbul… İnsanlık tarihiyle eş, binlerce yıldır sakinleri ile
[Devamını Oku]

Gençler İçin Rehber Kırk Beyit-2
On Birinci Beyit: Bir başka söyleyeni “Lâ”… Âyinedir bu âlem her şey Hak ile kâimMir’ât-ı Muhammed’den Allah görünür dâim (Lâ)Kâim: Ayakta(Bu âlem bir ayinedir, bu ayineye baktığımızda her şeyin Hak ile ayakta duruşunu seyrederiz. Bu
[Devamını Oku]

Allah Var Gam Yok
Hafız demek Fars edebiyatı demektir. Bugün bile Tahran sokaklarında bir seyyar satıcıyı çevirseniz size Hafız’dan birkaç şiir mutlaka okur. Farsçanın kulağa hoş gelen tınısıyla insan başka bir alemin kapısını aralar. Özellikle “Gam Mehor” (Gam Yeme)
[Devamını Oku]

Müştak Baba’nın Gönül Sızısı: Muharrem’dir Meded Ey Dil Muharrem
1759 senesinde Bitlis’te doğmuştur. Anne tarafından soyu Peygamberimize (sav) dayanmaktadır. Kadiri Şeyhi Hacı Hasan Şirvani’den dersler alarak ona intisab etmiştir. Hoca Neş’et’ten hadis-i şerif ve Mesnevi okumuştur. 75 yaşına yakın Muş’ta şehid edilmiştir. Şehid edilişinden
[Devamını Oku]

Şemseddin Sivasî’nin Bir Na’t-i Şerifi: Şefâ’at Yâ Resûlallâh
1520 senesinde Zile’de doğmuştur. Asıl adı Ahmed’dir. Esmerliğinden dolayı kendisine Kara Şems denilmiştir. Şems-i Tebrizi ve Ak Şemseddin ile birlikte üç Şems’ten biridir. Halvetiyye tarikatının Şemsiyye kolunun kurucusu olan Şeyh, Sivas’taki Meydan Camiine vaiz olmak
[Devamını Oku]

İman Nuru
Derin uykulardayım, uyandıran yok,Gözlerim semada, kirpikler fora,Çığlıklar var sanki kulaklarımda,Kimsesiz dört duvar arasındayım.Bir mum aydınlatıyor, hayal dünyamı,Almışım kalemi, mürekkebim yok,Ne yazsam nafile, ağlamıyorum,Bir nur aradım, bulamıyorum.İman nuru yetti, gördüm çareyi,Buldum bana beni vereni,Var olanda olan
[Devamını Oku]

Gençler İçin Rehber Kırk Beyit-3
Yirmi Birinci Beyit: Bir başka “Lâ”… Varsa aklın re’y ü tedbîrinde noksân eylemeÇünki noksân eyledin takdîre bühtân eyleme (Lâ)Re’y: Görüş, kanaat, oy / Bühtân: İftira(Akıllı adamın hali başkadır. Bir şeyi seçerken veya bir şeye tedbir
[Devamını Oku]

Gençler İçin Rehber Kırk Beyit-4
Otuz Birinci Beyit: Hayali Bey, Kanuni devri şairlerindendir. Vardar Yenicesi’nde doğan şair medrese tahsili görmemiş, Bostan ve Gülistan’ın tesiriyle yetişmiştir. Devrin en önemli şairi Fuzuli ile görüşmüşlüğü vardır. Hayatı boyunca pek çok ihsana kavuşmuş olmasına
[Devamını Oku]

Süleyman Çelebi’nin Mevlidinde Mi’râc
Süleyman Çelebi, “Vesiletü’n-Necat” ismini verdiği Mevlid-i Şerifini 15. asrın başında kaleme almıştır. Kendisinin tek eseri olan bu güzide eserin telif sebebi gayet manidardır:Süleyman Çelebi, “Vesiletü’n-Necat” ismini verdiği Mevlid-i Şerifini 15. asrın başında kaleme almıştır. Kendisinin
[Devamını Oku]

Akif’in Gençlik Şiirlerinden “Kur’ân’a Hitab”
Kur’ân ayı şehr-i Ramazan münasebetiyle…Merhum Mehmed Akif genç yaşında hafızlığını tamamlar. Bu esnada Kur’ân-ı Mu’cizü’l-beyân’ın imanına verdiği kuvvetle “Kur’ ân’a Hitab” isimli bir şiir yazar. Dört kısım ve 28 beyitten oluşan bu şiir, Mesnevi biçiminde
[Devamını Oku]

Mısri’nin “… Anlar Bizi” Redifli Şiirine Nazire
Yâ Rabbi! Bizi ve Risale-i Nûr talebelerini iki cihânda azîz ve mesûd eyle… Hüsn-i hâtimeye mazhar eyle… Şühedâ mertebesine vâsıl eyle… Hizmet-i îmâniye ve hizmet-i Kur’âniyede muvaffakiyet, muhabbet, ittifâk, tesânüd, mazhar-ı inâyet, mazhar-ı lütuf ihsân
[Devamını Oku]

Nesimî’nin Gül Bahçesinde Bir Yürüyüş
Bazı kelimeler vardır ki, yalnızca bir nesneyi, bir çiçeği ya da bir güzelliği anlatmaz; aynı zamanda bir medeniyetin ruhunu, bir halkın inancını, bir gönül adamının kalp ritmini dile getirir. Nesîmî’nin şiirinde “gül” böyle bir kelimedir.
[Devamını Oku]

Sultan Şair Muhibbi’nin Penceresinden Baharı Okumak
Metn-i hüsnünde hatun hattâtı yazmış hâşiyeŞerh idüb evrâk-ı gülden tâze defter baglamışDevr-i gülde bu Muhibbî yine yârân şevkine Tâze tâze gül gibi rengîn gazeller baglamışاِنَّهُ مِنْ سُلَيْمٰنَ وَ اِنَّهُ بِسْمِ اللّٰهِ الرَّحْمٰنِ الرَّحٖيمِ“Şübhesiz ki o,
[Devamını Oku]

Sadakat Timsali’ne (ra) “Sıddîk” Redifli Medhiyye
Şeyh Seyyid Mustafa Selami en-Nakşibendi. Şeyh babanın şeyh evladı…17. asırda İzmir’de doğmuş, Buhara’ya kadar bir miktar gezmiş, sonrasında İstanbul’da Eyübsultan’ı mesken tutmuştur. Bestelediği ilahilerinin ve tasavvufu işlemiş olduğu şiirinin yanı sıra kendisine tahsis edilen hoş
[Devamını Oku]

Divan Şairinin İzinde “Ayâsufiyye’de” Bir Tefekkür
Yusuf Nabi, en öz ifadesiyle “tefekkür şairi”dir. Onun imzasını taşıyan mısralar, beyitler ve kıt’alar kendi tefekküründen izler taşıdığı gibi okuyanı da kendi âleminde tefekküre sevk eder. Baş başa, kalb kalbe şöyle bir seyahat ettirir. Bu
[Devamını Oku]

Divan Şairinin İzinde “Ayâsufiyye’de” Bir Tefekkür (2)
Yedinci Beyit:Andelibân-ı bihişti şermle hâmûş iderHer taraf âvâze-i Kur’ân Ayâsufiyye’deAndelibân-ı bihişt: Cennet bülbülleri / Şerm: (fa.) Utanma / Hâmûş etmek: (fa.) Ağzını kapayıp sus olmak (Kur’ân sesi Ayasofya’da her tarafı öyle bir kaplamıştır ki Cennet
[Devamını Oku]

Şefaât Vesilesi, Su Kasidesi (1)
(Ey Resûlüm!) (Biz) seni ancak âlemlere bir rahmet olarak gönderdik. (Enbiyâ, 107)Elbette Seyyid-i Kâinat olan Efendimiz Rahmeten li’l-âlemîn’dir. Bu hakikati Rahman ve Rahim olan Rabbimiz, Hâlıkımız bizzat haber vermektedir. (وَمَٓا اَرْسَلْنَاكَ اِلَّا رَحْمَةً لِلْعَالَمٖينَ) (Ey
[Devamını Oku]

Şefâat Vesilesi, Su Kasidesi (2)
Hazret-i Muhammed’in gül yüzüne ölüm vakti gelene kadar her ân salât ü selâm getirmek, bana farz-ı ayn olsun. Milyonlar salât ve milyonlar selâm sana olsun, ey Allah’ın vahyinin Emîni!Men lebün müştâkıyam zühhâd kevser tâlibiNitekim meste
[Devamını Oku]

Şefâat Vesilesi, Su Kasidesi (3)
Mu’cizi bir bahr-ı bî-pâyân imiş ‘âlemde kimYetmiş andan min min âteş-hâne-i küffâra su[Onun (asm) mucizeleri âlemde öyle uçsuz bucaksız bir denizdir ki kâfirlerin kalbleri kasıp kavuran binlerce küfür ateşini söndürmeye kâfi gelir.] Mecusinin mabedine ne
[Devamını Oku]

Şiirlerin Dilinden Resûlullah (sav)
Her çağın karanlığı vardır. Ve her karanlık, kalbi üşütür. İnsan üşüyünce, sözler yetmez. İnsanın ruhu üşüyünce, akıl teselli bulmaz. İşte böyle zamanlarda insan, bir isme sığınır: Muhammed Mustafa (sallallahu aleyhi ve sellem).Adını anınca içimiz aydınlanır.
[Devamını Oku]

Şefâat Vesilesi, Su Kasidesi (4)
Yâ Habîballah yâ Hayre’l-beşer müştakunamEyle kim leb-teşneler yanub diler hemvâre su[Yâ Habîballah, yâ Hayre’l beşer, yâ, yâ, yâ, yâ, yâ (asm.)… Tâ esmâ-i Nebi’ce. Öyle sana iştiyakım var ki hani susamışlar yanıp kurumuş dudaklarıyla daima
[Devamını Oku]

Hüdaî Yolunda Bir Hikmetli Şiir: İnsan İsmine Kim Lâyık Ola!
“Sağlığımızda bizi, vefatımızdan sonra kabrimizi, ziyaret edenler ve türbemizin önünden geçtiğinde Fatiha okuyanlar bizimdir. Bizi sevenler denizde boğulmasın âhir ömürlerinde fakirlik çekmesin, imanlarını kurtarmadıkça göçmesin.” Cüneyd-i Bağdadi’nin neslinden…Seyyid.Bursa kadısı.Üftade müridi.Kalem ehli.Yûnus Emrem “hem-râh”ı.Şiirince, “Halifetullah”.Sultan Ahmed
[Devamını Oku]





